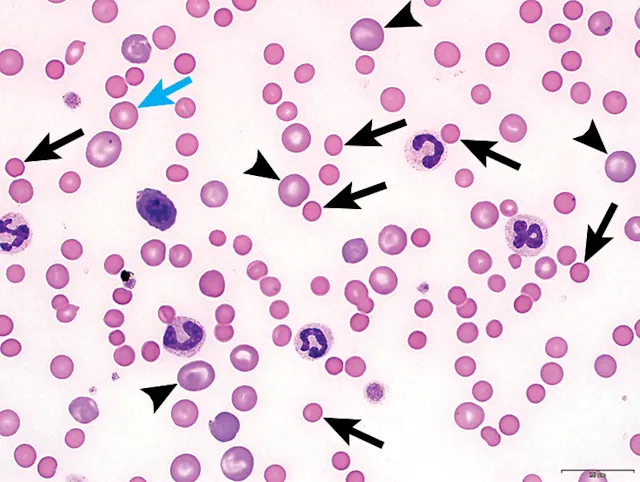
thumbnail image

Image Gallery: Red Blood Cell Evaluation in Blood Films
Lisa M. Pohlman, DVM, MS, DACVP, Kansas State University

Blood film evaluation is an important part of the routine CBC, as it often provides valuable diagnostic and prognostic information regarding the patient and the disorder being investigated. Ideally, a blood film should be evaluated as a part of every CBC.
Regular blood film evaluation can provide the practitioner with a breadth of experience, including a better understanding of normal variation among patients; an increased ability to recognize, and thus not overinterpret, the presence of common contaminants and artifacts that result from sample collection, preparation, and handling; an improved capacity to recognize morphologic abnormalities; and enhanced skill in determining when abnormal findings are clinically significant.
Even in cases when all CBC values are within the reference interval, abnormalities may be detected on the blood film. The following images and their interpretations focus on RBC morphology.
FIGURE 1
Immune-mediated hemolytic anemia with marked evidence of regeneration in a dog (black arrows) are smaller and a darker shade of pink; they lack central pallor as compared with a normal erythrocyte (blue arrow). Regeneration is supported by the frequent, large polychromatophilic erythrocytes (arrowheads), which are analogous to reticulocytes.
The spherocytes (black arrows) are smaller and a darker shade of pink; they lack central pallor as compared with a normal erythrocyte (blue arrow). Regeneration is supported by the frequent, large polychromatophilic erythrocytes (arrowheads), which are analogous to reticulocytes.